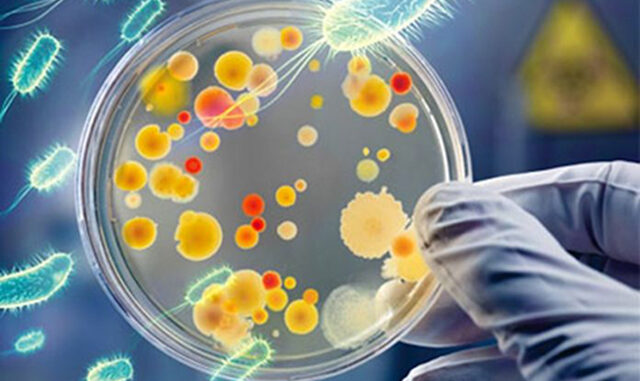

Antibióticos que no curan. Enfermedades que se creían superadas se vuelven intratables. Medicamentos que pierden eficacia a la hora de combatir una bacteria. En los tiempos que corren la resistencia a los antibióticos es la mayor amenaza sanitaria en el mundo. En la Semana Mundial de Concienciación sobre el Uso de los Antibióticos, el Municipio de San Isidro alerta acerca del uso inadecuado de los medicamentos. (Ver lo que tenés que saber).
“Cerca de 700 mil personas mueren por año por bacterias resistentes a los antibióticos. Esto ocurre porque al utilizarlos de manera inadecuada las bacterias se las ingenian para crear resistencia a los antibióticos”, explicó Elena Obieta, jefa del Servicio de Enfermedades Transmisibles y Emergentes del municipio.
¿Qué podemos hacer para evitarla? “No tomar antibióticos sin indicación médica; completar el esquema indicado de medicamentos (dosis, duración en días, aunque te sientas mejor); y no compartir antibióticos que te sobraron” son algunas de las claves afirmó la especialista.
“Los antibióticos curan solamente las enfermedades de origen bacteriano (no sirven para el resfrío, la gripe o anginas; bronquitis virales)”, completó Obieta.
Laura Figueras, jefa de sección de Infectología del Hospital Central, dimensionó: “Cada vez es mayor el número de infecciones (neumonía, tuberculosis, gonorrea y salmonelosis) y el tratamiento se vuelve más difícil debido a la pérdida de eficacia de los medicamentos. La resistencia a los antibióticos prolonga las estancias hospitalarias, incrementa los costos médicos y aumenta la mortalidad”.
Y sumó: “Si no se dispone de antibióticos eficaces para prevenir y tratar las infecciones, los trasplantes de órganos, la quimioterapia y las intervenciones quirúrgicas se volverán más peligrosas”.
Según la Organización Mundial de la Salud (OMS) -si no se corrige el uso excesivo e indebido de antibióticos en la atención de la salud humana y animal – para el 2050 la mortalidad será de 10 millones por año superando al cáncer y la diabetes.
Prevención y control: lo que tenés que saber
-Tomar antibióticos únicamente cuando los prescriba un profesional sanitario certificado.
-No pedir antibióticos si los profesionales sanitarios dicen que no son necesarios.
-Seguir siempre las instrucciones de los profesionales sanitarios con respecto al uso de los antibióticos.
-No utilizar los antibióticos que le hayan sobrado a otros.
-Prevenir las infecciones lavándose frecuentemente las manos, preparando los alimentos en condiciones higiénicas, evitando el contacto cercano con enfermos, adoptando medidas de protección en las relaciones sexuales y manteniendo las vacunaciones al día.
– Preparar los alimentos en condiciones higiénicas tomando como modelo las cinco claves para la inocuidad de los alimentos de la OMS (mantener la limpieza; separar alimentos crudos y cocinados; cocinar completamente; mantener los alimentos a temperaturas seguras; y usar agua y materias primas inocuas)
